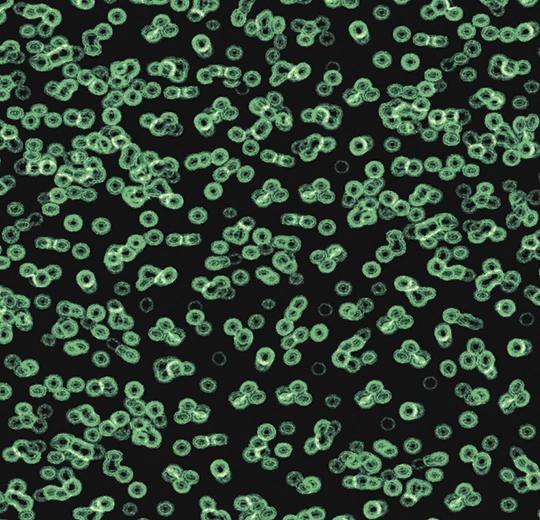

The Flotex Sottsass collection is created by Ettore Sottsass and Christopher Redfern of the Italian design studio Sottsass Associati and forms a radical direction in combining dynamic design with pioneering and innovative product technology. The collection compromises 3 designs: Terrazzo, Wool and Bacteria. The designs feature irregular, apparently random and organic forms, and the “optical” feature to play with scale, an aspect which is especially relevant to flooring, where the dynamics of perspective are constantly at work.Flotex Sottsass is available in a wide range of colourways and include hot fashion colours in strongly contrasting combinations like Schiapparelli pink, electric blue and neon green on a black background. A radical direction in combining dynamic design with pioneering and innovative product technology, that is the Sottsass Collection. A directional collection in Flotex flocked flooring, ground-breaking both aesthetically and technically.Flotex Sottsass is the res
Flotex by Sottsass
The Flotex Sottsass collection is created by Ettore Sottsass and Christopher Redfern of the Italian design studio Sottsass Associati and forms a radical direction in combining dynamic design with pioneering and innovative product technology. The coll

Reviews
There are no reviews yet.